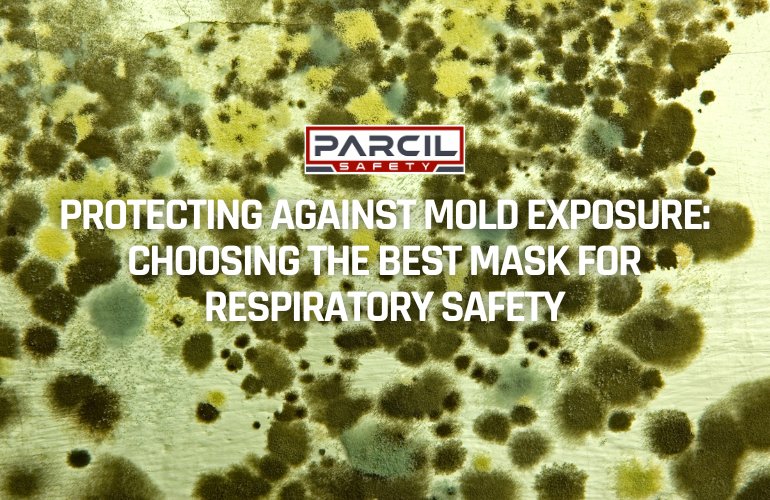
Protecting Against Mold Exposure: Choosing the Best Mask for Respiratory Safety - Parcil Safety

Mold is a common household hazard that poses serious health risks, especially in damp or humid environments. Mold spores, which become airborne as they spread, can lead to respiratory issues and worsen pre-existing conditions. According to the CDC, nearly 1 in 4 homes have indoor mold growth, putting millions at risk for respiratory complications. In this article, we’ll explore effective ways to prevent mold-related illness, including proper respiratory protection to ensure your safety when dealing with mold exposure.
Why Mold Protection is Essential for Health

Exposure to mold spores can lead to health complications ranging from mild allergic reactions to more severe respiratory illnesses. Up to 21% of respiratory illnesses in buildings with visible mold are attributed to exposure. People with asthma, allergies, or compromised immune systems are especially vulnerable, and prolonged exposure can lead to chronic symptoms or severe lung infections.
Common health symptoms related to mold exposure include:
- Persistent coughing and sneezing
- Sore throat
- Shortness of breath
- Irritated eyes and skin
The right precautions and respiratory protection can minimize these risks and help you work safely in mold-prone areas.
Get Mold Protection Gas Masks Here
Best Practices for Mold Prevention

Mold thrives in moist environments. Areas like basements, bathrooms, kitchens, and places prone to leaks are common mold hotspots. Preventing mold is essential to minimizing exposure and should be part of regular home maintenance. Key prevention methods include:
- Maintain Proper Ventilation: Ensure air circulation in all rooms. Use fans and open windows to reduce humidity, particularly in kitchens and bathrooms.
- Control Humidity Levels: Mold grows when indoor humidity exceeds 60%. Use dehumidifiers to keep humidity levels below 50%, especially in basements.
- Address Leaks Promptly: Any leaks in the roof, walls, or plumbing should be fixed immediately. Mold can develop within 24-48 hours of water exposure.
- Regular Cleaning and Disinfection: Clean bathrooms, kitchens, and damp areas regularly. Use mold-resistant cleaning solutions, especially in high-humidity areas.
- Use Mold-Resistant Products: Opt for mold-resistant drywall, paint, and insulation in moisture-prone areas to reduce mold growth potential.
Explore Industrial-Grade Gas Masks Here
Respiratory Protection Against Mold
When dealing with mold, wearing a high-quality respirator is crucial. Respirators protect the lungs from harmful spores and other particles that can be inhaled during cleaning or mold remediation. For mold protection, consider the following types of masks:
- N95 Respirators: These masks are widely available and offer significant protection against airborne particles, including mold spores. N95 masks filter out at least 95% of airborne particles, making them effective for small mold removal tasks. However, N95 respirators may not be sufficient for large-scale mold remediation.

- Half-Face Respirators with P100 Filters: For more extensive protection, half-face respirators equipped with P100 filters provide superior filtration, blocking up to 99.97% of particles. These respirators also offer a snug fit, reducing the chance of inhaling dangerous spores.

- Full-Face Respirators: For environments with high mold concentrations, full-face respirators provide the most comprehensive protection. They shield the nose, mouth, and eyes, preventing spore inhalation and eye irritation. Parcil Satefy's P-3-O canister offers reliable protection, especially for individuals involved in large-scale mold remediation or construction work in mold-prone buildings.

- Reusable Respirators with Replaceable Filters: If mold exposure is a regular concern, investing in a reusable respirator with replaceable filters can be cost-effective and convenient. Filters such as the P3 or P100, recommended for heavy-duty applications, provide excellent protection against mold spores and other particulates.
Choosing the Right Respiratory Protection: What to Consider
When selecting respiratory protection for mold exposure, consider these factors:
Type of Mold Exposure: For minor mold exposure, an N95 mask may suffice. For significant exposure, especially in confined spaces, consider a half-face or full-face respirator.
Fit and Comfort: Ensure a proper fit to maximize protection and comfort during prolonged use.
Filter Replacement: For reusable respirators, change filters regularly according to the manufacturer's guidelines to maintain optimal protection.
Get Mold Protection Gas Masks Here
Tips for Safe Mold Removal

If mold growth is small and manageable, follow these safety tips to remove it effectively:
- Wear gloves, goggles, and a respirator to protect yourself from spores.
- Use an EPA-registered mold-removing solution.
- Avoid dry-scrubbing mold. Instead, use a damp cloth or sponge to prevent spores from becoming airborne.
- Ventilate the area by opening windows or using exhaust fans to prevent buildup of spores.
For severe mold infestations, it’s best to contact a professional mold remediation service. They have the expertise and equipment to handle large areas safely.
Get Mold Protection Gas Masks Here
Products and Resources for Mold Safety
When selecting respiratory protection, choose reputable brands and suppliers. Parcil Safety offers high-quality respirators and filters designed for mold and other hazardous environments. Explore our collection here to find the best solution for your needs.
Conclusion
Protecting yourself from mold exposure is crucial to safeguarding your health. With proper ventilation, humidity control, and reliable respiratory protection, you can effectively prevent mold growth and minimize the risk of exposure. For optimal respiratory safety, choose a well-fitted respirator with the appropriate filters for mold exposure, such as the P100 or full-face options.
For more information on respiratory protection and mold safety, visit Parcil Safety’s blog and explore our selection of reliable safety products. Stay safe, and remember, prevention and protection are your best defenses against mold.

Leave a comment
All comments are moderated before being published.
This site is protected by hCaptcha and the hCaptcha Privacy Policy and Terms of Service apply.